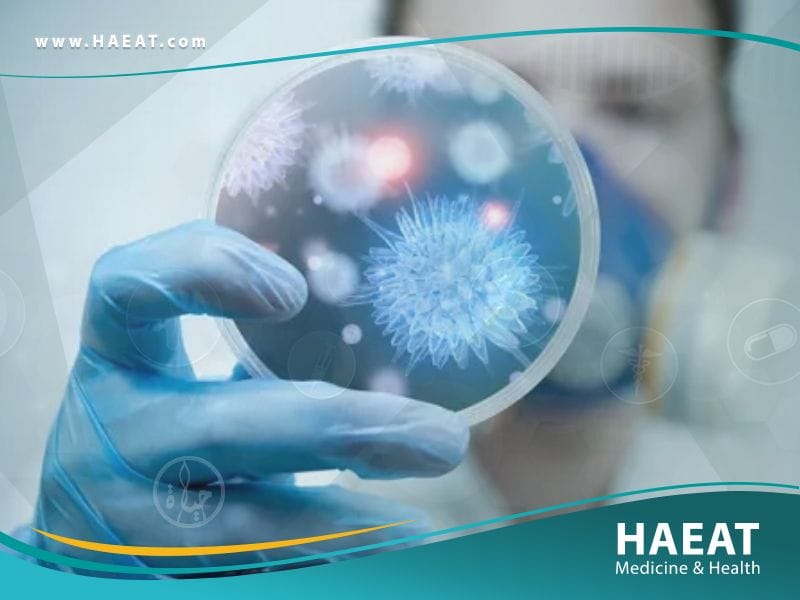
ما هو فيروس كورونا

يُعد فيروس كورونا (Coronavirus)، المعروف علمياً باسم SARS-CoV-2 والمسبب لمرض “كوفيد-19″، تحدياً صحياً عالمياً يتطلب فهماً دقيقاً لآليات العدوى وبروتوكولات العلاج المتطورة باستمرار. في “مدونة حياة الطبية”، نقدم لك دليلاً طبياً محكماً يستند إلى أحدث الأبحاث السريرية لمساعدتك على التعامل مع الإصابة والوقاية منها بوعي كامل.
ما هو فيروس كورونا؟
ما هو فيروس كورونا هو سلالة فيروسية واسعة الانتشار تنتمي لعائلة الفيروسات التاجية، والتي تسبب أمراضاً تتراوح بين نزلات البرد الشائعة والمتلازمات التنفسية الحادة.
تحديداً، يُعرف المستجد باسم (SARS-CoV-2)، وهو فيروس حمض نووي ريبوزي (RNA) ينتقل بشكل أساسي عبر الجهاز التنفسي. وفقاً للمعاهد الوطنية للصحة (NIH)، يهاجم الفيروس الخلايا المبطنة للمسالك الهوائية والرئتين من خلال الارتباط بمستقبلات ACE2، مما يؤدي إلى استجابة مناعية قد تتطور إلى التهاب رئوي حاد أو فشل في وظائف الأعضاء في الحالات المتقدمة. لا يقتصر تأثير ما هو فيروس كورونا على الرئتين فحسب، بل يُعد مرضاً وعائياً وجهازياً قد يؤثر على القلب، الكلى، والدماغ.

أعراض ما هو فيروس كورونا
تتفاوت أعراض ما هو فيروس كورونا بشكل كبير بين المصابين، حيث تتراوح من عدم ظهور أي علامات (Asymptomatic) إلى حالات حرجة، وغالباً ما تظهر الأعراض بعد فترة حضانة تمتد من 2 إلى 14 يوماً من التعرض للعدوى.

تشمل العلامات السريرية الموثقة في الدوريات الطبية (مثل The Lancet) ثلاث فئات رئيسية:
الأعراض الأكثر شيوعاً ل ما هو فيروس كورونا:
- الحمى والقشعريرة: ارتفاع درجة الحرارة هو أحد المؤشرات المناعية الأولى لمحاربة العدوى.
- السعال الجاف والمستمر: تهيج في الجهاز التنفسي قد يستمر لأسابيع.
- الإرهاق الشديد (Fatigue): شعور بالوهن العام وآلام في العضلات والجسم (Myalgia).
- فقدان حاسة الشم أو التذوق (Anosmia/Ageusia): علامة مميزة جداً لـ فيروس كورونا ناتجة عن تأثير الفيروس على الخلايا العصبية الداعمة.
الأعراض الأقل شيوعا” ل ما هو فيروس كورونا:
- التهاب الحلق: شعور بالألم أو الحكة في البلعوم.
- الصداع: آلام رأس قد تكون حادة ومستمرة.
- الاحتقان وسيلان الأنف: تتشابه مع أعراض الإنفلونزا الموسمية.
- الأعراض الهضمية: تشمل الغثيان، القيء، والإسهال، وقد تسبق الأعراض التنفسية أحياناً.
- التهاب الملتحمة (العيون الوردية): احمرار وتهيج في العين.
- الطفح الجلدي: تغيرات في لون الجلد أو تورم في أصابع اليدين والقدمين (ما يعرف بـ “أصابع كوفيد”).
الأعراض الخطيرة ل ما هو فيروس كورونا (تستدعي الطوارئ):
- صعوبة التنفس (Dyspnea): الإحساس بضيق شديد وعدم القدرة على ملء الرئتين بالهواء.
- ألم أو ضغط مستمر في الصدر: مؤشر محتمل لنقص الأكسجة أو مشاكل قلبية.
- الارتباك الجديد (New Confusion): عدم القدرة على الاستيقاظ أو البقاء مستيقظاً.
- تغير لون الجلد أو الشفاه أو الأظافر: الميل إلى اللون الشاحب أو الأزرق (Cyanosis) نتيجة نقص الأكسجين.

أسباب ما هو فيروس كورونا
يحدث مرض كوفيد-19 نتيجة الإصابة بعدوى فيروس كورونا المستجد (SARS-CoV-2)، وتكمن الأسباب الرئيسية في آليات الانتقال الفيروسي وسرعة تكاثره داخل المضيف البشري.
تنتقل عدوى (ما هو فيروس كورونا) عبر الطرق التالية المثبتة علمياً:
- الرذاذ التنفسي (Respiratory Droplets): السبب الرئيسي للعدوى؛ حيث يطلق المصاب قطرات صغيرة عند السعال، العطس، التحدث، أو حتى التنفس، والتي قد يستنشقها شخص قريب أو تدخل عبر الأغشية المخاطية (العين، الأنف، الفم).
- الانتقال عبر الهواء (Airborne Transmission): في الأماكن المغلقة وسيئة التهوية، يمكن للجسيمات الفيروسية الدقيقة (Aerosols) أن تبقى معلقة في الهواء وتنتقل لمسافات أبعد من مترين، مما يسهل استنشاق فيروس كورونا.
- ملامسة الأسطح الملوثة (Fomites): على الرغم من أنها أقل شيوعاً مقارنة بالانتقال التنفسي، إلا أن لمس سطح ملوث بالفيروس ثم لمس الوجه قد يؤدي للعدوى.
- العدوى من الأشخاص بدون أعراض: تشير دراسات مراكز السيطرة على الأمراض والوقاية منها (CDC) إلى أن نسبة كبيرة من انتقال العدوى تحدث من أشخاص لا تظهر عليهم أي أعراض واضحة، مما يعقد جهود السيطرة.
- الطفرات الجينية (المتحورات): قدرة الفيروس على التغير جينياً تؤدي لظهور سلالات جديدة (مثل دلتا وأوميكرون) قد تكون أكثر قدرة على الانتشار أو الهروب من المناعة المكتسبة.
متى تزور الطبيب؟
يجب التعامل مع اشتباه الإصابة بـ (ما هو فيروس كورونا) بحذر، حيث يعتمد توقيت زيارة الطبيب أو المستشفى على شدة الأعراض والفئة العمرية للمريض، مع ضرورة عزل النفس فوراً لحماية الآخرين.
إرشادات للبالغين
بالنسبة للبالغين، يمكن إدارة معظم الحالات الخفيفة في المنزل. ومع ذلك، يجب طلب الرعاية الطبية الفورية إذا تطورت الحالة إلى مرحلة نقص الأكسجة الصامت أو ظهرت العلامات التالية:
- انخفاض نسبة تشبع الأكسجين في الدم (SpO2) عن 92-94% عند قياسها بجهاز قياس التأكسج النبضي المنزلي.
- صعوبة متزايدة في التنفس حتى أثناء الراحة أو بذل مجهود بسيط.
- ألم مستمر في الصدر لا يستجيب للمسكنات.
- عدم القدرة على الكلام بجمل كاملة دون التوقف لالتقاط الأنفاس.
- علامات الجفاف الشديد (مثل قلة التبول، الدوخة عند الوقوف).
إرشادات خاصة بالأطفال
على الرغم من أن الأطفال غالباً ما يعانون من أعراض أخف عند الإصابة بـ فيروس كورونا، إلا أن هناك حالات نادرة وخطيرة مثل “متلازمة التهاب الأجهزة المتعددة لدى الأطفال” (MIS-C). يجب مراجعة الطبيب فوراً إذا لاحظت:
- حمى استمرت لأكثر من 3 أيام.
- طفح جلدي غير مبرر، أو احمرار شديد في العينين والشفتين.
- ألم شديد في البطن، قيء، أو إسهال مستمر.
- خمول غير عادي، تهيج، أو صعوبة في الاستيقاظ.
- تنفس سريع أو شخير أثناء التنفس (Grunting).
خيارات التطبيب عن بعد (Telehealth)
لتقليل خطر نشر العدوى أو التعرض لها في غرف الانتظار، يُنصح بشدة باستخدام خيارات التطبيب عن بعد كخطوة أولى.
- التقييم الأولي: يمكن للأطباء تقييم شدة الأعراض عبر الفيديو وتوجيه المريض لإجراء فحص PCR أو التوجه للطوارئ إذا لزم الأمر.
- المتابعة المنزلية: تتيح التطبيقات الصحية متابعة العلامات الحيوية (الحرارة، الأكسجين) عن بُعد تحت إشراف طبي، مما يضمن تدخلاً سريعاً في حال تدهور الحالة الصحية بسبب فيروس كورونا.

عوامل الخطر والإصابة بـ (ما هو فيروس كورونا)
لا تؤثر عدوى (ما هو فيروس كورونا )على الجميع بنفس الدرجة؛ فهناك فئات محددة تمتلك قابلية بيولوجية ومناعية تجعلها أكثر عرضة للإصابة بمضاعفات خطيرة أو الوفاة، وفقاً لتحليلات مراكز السيطرة على الأمراض (CDC).
تشمل عوامل الخطر الرئيسيةل (ما هو فيروس كورونا) التي تتطلب يقظة مضاعفة:
- التقدم في العمر: يزداد خطر الإصابة الشديدة بشكل ملحوظ مع التقدم في السن، خاصة لمن هم فوق 65 عاماً، نتيجة لشيخوخة الجهاز المناعي (Immunosenescence).
- الأمراض المزمنة الكامنة:
- أمراض القلب والأوعية الدموية: مثل قصور القلب وارتفاع ضغط الدم.
- السكري (النوع 1 و 2): ارتفاع سكر الدم يضعف استجابة الخلايا المناعية ضد فيروس كورونا.
- أمراض الرئة المزمنة: مثل الانسداد الرئوي المزمن (COPD) والربو الحاد.
- السمنة المفرطة: وجود مؤشر كتلة جسم (BMI) مرتفع يرتبط بزيادة الالتهاب المزمن وضعف وظائف الرئة الميكانيكية.
- ضعف الجهاز المناعي: سواء كان ناتجاً عن حالات مرضية (مثل السرطان، فيروس نقص المناعة البشرية) أو علاجات مثبطة للمناعة (مثل الكورتيزون، العلاج الكيميائي).
- الحمل: التغيرات الفسيولوجية أثناء الحمل قد تجعل النساء أكثر عرضة للمضاعفات التنفسية مقارنة بغير الحوامل.
- التدخين: يضر التدخين بالأهداب المبطنة للرئة التي تنقي الهواء، مما يسهل اختراق الفيروس للأنسجة العميقة.
مضاعفات (ما هو فيروس كورونا)
قد يتجاوز تأثير كوفيد-19 الجهاز التنفسي ليسبب تدهوراً جهازياً شاملاً، حيث تظهر الدراسات السريرية أن فيروس كورونا يمكن أن يؤدي إلى مضاعفات قصيرة وطويلة الأمد قد تكون مهددة للحياة.
تتضمن المضاعفات الطبية الموثقة ل (ما هو فيروس كورونا) ما يلي:
- الالتهاب الرئوي ومتلازمة الضائقة التنفسية الحادة (ARDS): امتلاء الأكياس الهوائية بالسوائل، مما يمنع وصول الأكسجين للدم ويتطلب غالباً دعماً تنفسياً ميكانيكياً.
- جلطات الدم (Thrombosis): يزيد الفيروس من لزوجة الدم، مما يرفع خطر حدوث جلطات في الساقين، الرئتين (الانصمام الرئوي)، أو الدماغ (السكتة الدماغية).
- إصابات القلب الحادة: التهاب عضلة القلب (Myocarditis) أو اضطراب نظم القلب، حتى لدى المرضى الذين لا يعانون من تاريخ مرضي قلبي.
- تلف الكلى الحاد: قد يحتاج بعض المصابين لغسيل كلوي مؤقت نتيجة الهجوم الفيروسي المباشر أو نقص الأكسجين.
- العدوى البكتيرية الثانوية: إصابة الرئتين المنهكتين ببكتيريا إضافية، مما يعقد بروتوكول العلاج.
- فشل الأعضاء المتعدد (Multiorgan Failure): انهيار وظائف عدة أجهزة حيوية في الجسم نتيجة عاصفة السيتوكين (استجابة مناعية مفرطة).
الوقاية من (ما هو فيروس كورونا)
تعتمد الوقاية الفعالةل (ما هو فيروس كورونا) على نهج “الدفاع متعدد الطبقات”، حيث لا يكفي إجراء واحد لصد فيروس كورونا، بل يجب دمج عدة استراتيجيات لتقليل الحمل الفيروسي المحتمل في البيئة المحيطة.

إليك البروتوكول الوقائي الشامل الموصى به من قبل الهيئات الصحية العالمية:
- التطعيم الكامل والجرعات المعززة: اللقاحات المعتمدة (mRNA وغيرها) هي الخط الدفاعي الأول لتقليل خطر المرض الشديد والوفاة، حتى مع ظهور متحورات جديدة.
- ارتداء الكمامات عالية الجودة: يُنصح باستخدام كمامات N95 أو KN95 في الأماكن المغلقة والمزدحمة، حيث توفر حماية أفضل من الكمامات القماشية ضد الجزيئات الدقيقة (Aerosols).
- التهوية الجيدة (Ventilation): تحسين تدفق الهواء في الأماكن المغلقة وفتح النوافذ يقلل تركيز الجسيمات الفيروسية العالقة بشكل كبير.
- التباعد الجسدي: الحفاظ على مسافة آمنة (حوالي مترين) يقلل احتمالية استنشاق الرذاذ المباشر.
- نظافة اليدين الصارمة: غسل اليدين بالماء والصابون لمدة 20 ثانية على الأقل، أو استخدام معقم كحولي بتركيز 60% كحد أدنى، لقتل غشاء الفيروس الدهني.
- تجنب لمس الوجه: العين والأنف والفم هي بوابات دخول الفيروس الرئيسية للجسم.

تشخيص (ما هو فيروس كورونا)
لتحديد الإصابة بدقة، يعتمد الأطباء على فحوصات مخبرية محددة تكشف عن المادة الوراثية للفيروس أو البروتينات الخاصة به، مما يساعد في عزل المصاب بـ فيروس كورونا مبكراً ومنع تفشي العدوى.
أنواع الفحوصات المعتمدة:
- فحص تفاعل البوليميراز المتسلسل (RT-PCR): يُعد “المعيار الذهبي” للتشخيص. يتميز بدقة عالية جداً في الكشف عن الحمض النووي للفيروس حتى بكميات ضئيلة. تُؤخذ العينة عادة من الأنف أو البلعوم، وتستغرق النتائج من ساعات إلى يوم.
- فحص المستضدات السريع (Rapid Antigen Test): يكشف عن بروتينات معينة على سطح الفيروس. يتميز بالسرعة (15-30 دقيقة) وإمكانية إجرائه منزلياً، لكنه أقل دقة من PCR وقد يعطي نتائج سلبية خاطئة إذا كان الحمل الفيروسي منخفضاً.
- فحوصات الأجسام المضادة (Serology): لا تُستخدم لتشخيص الإصابة الحالية، بل لمعرفة ما إذا كان الشخص قد أصيب سابقاً وكون مناعة، حيث تبحث عن الأجسام المضادة في الدم.
- التصوير الطبي: قد يُطلب إجراء أشعة سينية (X-ray) أو أشعة مقطعية (CT Scan) للصدر لتقييم مدى تأثر الرئتين ووجود التهاب رئوي، خاصة في الحالات التي تظهر أعراضاً تنفسية حادة رغم سلبية المسحة أحياناً.
العلاج من(ما هو فيروس كورونا)
لا يوجد علاج سحري واحد يقضي على كوفيد-19 فوراً، وتعتمد الخطة العلاجية التي نوصي بها في “موقع حياة الطبي” على شدة الأعراض وتاريخ المريض الصحي، بهدف تخفيف المضاعفات ودعم الجهاز المناعي.
1. نمط الحياة والعلاجات المنزلية (للحالات الخفيفة)
معظم المصابين بـ (ما هو فيروس كورونا) يتعافون في المنزل باتباع إجراءات داعمة:
- الراحة التامة: لتمكين الجسم من توجيه طاقته لمحاربة العدوى.
- الترطيب المكثف: شرب كميات وافرة من الماء والسوائل لتعويض الفقد الناتج عن الحمى ومنع الجفاف.
- وضعية الانكباب (Proning): الاستلقاء على البطن لفترات متقطعة يساعد في تحسين تهوية الرئتين وتسهيل التنفس.
- مراقبة الأكسجين: استخدام جهاز قياس التأكسج النبضي (Pulse Oximeter) لمراقبة تشبع الأكسجين والتأكد من عدم انخفاضه عن المعدل الطبيعي.
2. العلاجات الدوائية (حسب البروتوكولات الطبية)
للبالغين:
- مضادات الفيروسات الفموية: مثل (Nirmatrelvir/Ritonavir) المعروف تجارياً بـ “باكسلوفيد”، يُستخدم في الأيام الخمسة الأولى من الأعراض للحالات المعرضة للخطر لمنع تطور المرض.
- الستيرويدات القشرية (Corticosteroids): مثل “ديكساميثازون”، تُستخدم فقط للحالات التي تحتاج لأكسجين إضافي لتقليل الالتهاب المفرط. (تحذير: لا تُستخدم في الحالات الخفيفة لأنها قد تضعف المناعة).
- مسيلات الدم: جرعات وقائية لمنع تكون الجلطات لدى المرضى في المستشفى.
للأطفال:
- العلاج غالباً ما يكون داعماً (خافضات حرارة مثل الباراسيتامول، وسوائل).
- في الحالات النادرة والخطيرة، قد يصف الأطباء مضادات فيروسية محددة أو علاجات مناعية تحت إشراف دقيق في المستشفى، خاصة عند الاشتباه بمتلازمة (MIS-C).
3. مضادات الفيروسات الموجهة وآلية عملها
تعمل مضادات الفيروسات الحديثة المخصصة لمواجهة فيروس كورونا بآلية دقيقة تسمى “تثبيط البروتياز”. يقوم الدواء بمنع الإنزيم الذي يحتاجه الفيروس لنسخ نفسه داخل خلايا الجسم. وبدلاً من قتل الفيروس مباشرة، يوقف هذه الأدوية عملية تكاثره، مما يمنح الجهاز المناعي فرصة للسيطرة على العدوى قبل أن تنتشر وتسبب ضرراً واسعاً للأنسجة.
4. دور الأجسام المضادة أحادية النسيلة (Monoclonal Antibodies)
هذه تقنية علاجية متطورة عبارة عن بروتينات يتم تصنيعها مخبرياً لتعمل كأجسام مضادة طبيعية. يتم حقنها في جسم المريض لترتبط بـالشوكة البروتينية (Spike Protein) الخاصة بـ فيروس كورونا، مما يمنعه من دخول الخلايا البشرية. أثبتت هذه العلاجات فعاليتها في تقليل معدلات دخول المستشفى والوفيات عند إعطائها مبكراً للفئات عالية الخطورة، وتعتبر خياراً حيوياً لمن يعانون من ضعف في تكوين استجابة مناعية طبيعية.

الطب البديل و(ما هو فيروس كورونا)
على الرغم من عدم وجود “علاج عشبي” معتمد علمياً للقضاء على (ما هو فيروس كورونا)، إلا أن بعض المكملات الغذائية قد تلعب دوراً داعماً في تعزيز كفاءة الجهاز المناعي، بشرط عدم استبدالها بالعلاجات الطبية المقررة.
وفقاً للمركز الوطني للصحة التكميلية والتكاملية (NCCIH)، تشمل الخيارات الأكثر بحثاً:
- فيتامين D: تشير الدراسات إلى أن نقص مستويات فيتامين D قد يرتبط بزيادة خطر الإصابة بالتهابات تنفسية حادة. المكملات قد تساعد في تنظيم الاستجابة المناعية.
- الزنك (Zinc): يلعب دوراً حاسماً في وظيفة الخلايا المناعية، وقد تساعد أقراص الزنك (lozenges) في تقليل مدة نزلات البرد، لكن تأثيرها المباشر على كوفيد-19 لا يزال قيد الدراسة المكثفة.
- فيتامين C: مضاد أكسدة قوي يدعم وظائف الخلايا المناعية، وغالباً ما يُستخدم لتقليل شدة الأعراض التنفسية.
- البروبيوتيك (Probiotics): تعزيز صحة الأمعاء (حيث توجد نسبة كبيرة من الخلايا المناعية) قد يدعم الصحة العامة للجسم في مواجهة العدوى.
تحذير: بعض المكملات قد تتفاعل سلباً مع الأدوية (مثل مسيلات الدم). استشر طبيبك دائماً قبل البدء بأي مكمل غذائي.
الاستعداد لموعدك مع الطبيب
عند الشك في الإصابة بـ ( ما هو فيروس كورونا)، تتطلب زيارة الطبيب أو المستشفى تحضيراً خاصاً لحماية نفسك والآخرين، وضمان الحصول على تقييم دقيق لحالتك الصحية.
ما الذي يمكنك فعله؟
- الاتصال المسبق: أبلغ العيادة أو المستشفى بأعراضك قبل الذهاب ليتمكنوا من تجهيز غرفة عزل أو استقبالك عبر مدخل خاص.
- تدوين سجل الأعراض: سجل تواريخ بدء الحمى، قراءات الأكسجين (إذا توفرت)، وأي أدوية تتناولها حالياً.
- بروتوكول العزل الآمن : ارتدِ كمامة طبية عالية الكفاءة (N95) قبل الخروج، تجنب المواصلات العامة، واستخدم سيارة خاصة مع فتح النوافذ للتهوية، وحاول عدم لمس الأسطح في منطقة الانتظار.
ما الذي تتوقعه من طبيبك؟
سيطرح الطبيب أسئلة محددة لتقييم المخاطر: “منذ متى بدأت الأعراض؟ هل خالطت شخصاً مصاباً؟ هل تعاني من أمراض مزمنة؟” وقد يقوم بقياس نسبة الأكسجين وفحص الصدر بالسماعة لتقييم تدفق الهواء في الرئتين.
مراحل الشفاء من (ما هو فيروس كورونا)
تختلف رحلة التعافي من فيروس كورونا بناءً على شدة الإصابة والحالة الصحية للمريض، حيث يقسم الأطباء مسار الشفاء إلى مراحل زمنية تقريبية.
الجدول الزمني المتوقع للتعافي:
- الأسبوع الأول (الأعراض الحادة): تظهر الحمى، السعال، والتعب. يبدأ الجسم في إنتاج الأجسام المضادة. معظم الحالات الخفيفة تبدأ بالتحسن بنهاية هذا الأسبوع.
- الأسبوع الثاني (المنعطف الحرج): في الحالات المتوسطة للشديدة، قد تظهر صعوبة التنفس أو الالتهاب الرئوي بين اليوم 7-10. تتطلب هذه المرحلة مراقبة دقيقة للأكسجين.
- الأسبوع الثالث وما بعده (التعافي التدريجي): تبدأ الأعراض في الانحسار، لكن التعب والسعال الجاف قد يستمرا لأسابيع. يستعيد معظم المرضى عافيتهم الكاملة خلال 2-4 أسابيع، بينما قد يحتاج مرضى العناية المركزة لأشهر من التأهيل الرئوي والبدني.
الأنواع الشائعة ومتحورات (ما هو فيروس كورونا)
يتميز فيروس كورونا بقدرته على التحور الجيني المستمر للتكيف مع المضيف البشري، مما أدى لظهور سلالات (Variants) صنفتها منظمة الصحة العالمية إلى “متحورات مثيرة للاهتمام” و”متحورات مثيرة للقلق”.
أبرز المتحورات التي تم رصدها:
- متحور ألفا (Alpha): أول السلالات المتحورة الرئيسية، تميز بسرعة انتشاره مقارنة بالسلالة الأصلية.
- متحور دلتا (Delta): كان أكثر شراسة وتسبباً في إصابات رئوية حادة، وارتبط بموجات وبائية شديدة عالمياً.
- متحور أوميكرون (Omicron): يتميز بعدد هائل من الطفرات في بروتين الشوكة، مما جعله الأسرع انتشاراً والأكثر قدرة على الهروب الجزئي من المناعة، لكنه يميل لإصابة الجهاز التنفسي العلوي مسبباً أعراضاً أقل حدة من “دلتا”.
- السلالات الفرعية (Sub-variants): تستمر سلالة أوميكرون في التفرع (مثل BA.5, XBB, JN.1)، مما يستدعي تحديث اللقاحات دورياً.
متلازمة ما بعد كورونا (كوفيد طويل الأمد)
تُعرف طبياً بـ “Post-Acute Sequelae of SARS-CoV-2″، وهي حالة صحية معقدة يعاني فيها المتعافون من فيروس كورونا من أعراض مستمرة لأكثر من 4 أسابيع أو حتى أشهر بعد التعافي الأولي. تشمل هذه الأعراض “ضبابية الدماغ” (Brain Fog)، الإرهاق المزمن، خفقان القلب، وضيق التنفس عند الجهد، وتحدث حتى لمن كانت إصابتهم خفيفة، مما يتطلب متابعة طبية متعددة التخصصات في “موقع HAEAT الطبي”.
آلية انتقال عدوى(ما هو فيروس كورونا) بالتفصيل
لفهم كيفية الوقاية، يجب إدراك فيزياء الانتقال. ينتقل فيروس كورونا عبر “الهباء الجوي” (Aerosols) – وهي قطرات مجهرية تخرج مع الزفير وتبقى معلقة في الهواء كالدخان في الغرف سيئة التهوية لساعات. تشير دراسات مجلة JAMA إلى أن التركيز العالي للفيروس في هذه الجسيمات يجعل التنفس في غرفة مغلقة مع مصاب (حتى بدون سعال) خطراً كبيراً، مما يفسر أهمية تنقية الهواء وارتداء الكمامات المحكمة وليس مجرد التباعد.
تأثير (ما هو فيروس كورونا) على الصحة النفسية
لا تقتصر تداعيات الجائحة على الصحة الجسدية؛ فقد رصدت دراسات The Lancet Psychiatry ارتفاعاً حاداً في معدلات القلق، الاكتئاب، واضطرابات النوم المرتبطة بـ فيروس كورونا. يساهم العزل الاجتماعي، الخوف من العدوى، والحزن على الفقد في تفاقم هذه الحالات. نؤكد في “مدونة HAEAT الطبية” على ضرورة دمج الدعم النفسي ضمن خطة العلاج، حيث أن التوتر المزمن يضعف المناعة ويعيق عملية الشفاء الجسدي.
التغذية والمناعة في مواجهة(ما هو فيروس كورونا)
التغذية السليمة هي الوقود الذي يحتاجه جهازك المناعي لإنتاج الأجسام المضادة والخلايا التائية المقاتلة ضد فيروس كورونا.
الاستراتيجية الغذائية المقترحة:
- البروتينات عالية الجودة: ضرورية لبناء الخلايا المناعية (مثل البيض، الأسماك، البقوليات).
- الأطعمة المضادة للالتهاب: التركيز على الخضروات الورقية، التوت، المكسرات، وزيت الزيتون لتقليل الالتهاب الجهازي.
- التقليل من السكريات المكررة: السكر قد يثبط عمل خلايا الدم البيضاء مؤقتاً.
- الترطيب: الماء ضروري لنقل العناصر الغذائية والحفاظ على رطوبة الأغشية المخاطية التنفسية، وهي خط الدفاع الأول.
خرافات شائعة حول (ما هو فيروس كورونا)
تنتشر المعلومات المغلوطة بسرعة تفوق سرعة الفيروس نفسه، وتصحيحها جزء أساسي من الوعي الصحي.
- خرافة: “المضادات الحيوية تعالج كورونا.”
- الحقيقة: المضادات الحيوية تقتل البكتيريا فقط ولا تؤثر إطلاقاً على الفيروسات. استخدامها دون داعٍ يسبب مقاومة البكتيريا للأدوية.
- خرافة: “الطقس الحار يقتل الفيروس.”
- الحقيقة: ينتشر فيروس كورونا في كافة المناخات، بما فيها الدول ذات الطقس الحار والرطب. حرارة الشمس لا “تعقم” الجسم من الداخل.
- خرافة: “شبكات الجيل الخامس (5G) تنشر الفيروس.”
- الحقيقة: خرافة لا أساس لها علمياً. الفيروسات كائنات بيولوجية لا تنتقل عبر موجات الراديو أو الشبكات الكهرومغناطيسية.
- خرافة: “حبس النفس لمدة 10 ثوانٍ دون سعال يعني عدم الإصابة.”
- الحقيقة: هذا الاختبار غير دقيق، فالعديد من المصابين (خاصة الشباب) يمكنهم حبس أنفاسهم رغم وجود التهاب رئوي أو إصابة مؤكدة.
نصائح ذهبية من “مجلة حياة الطبية” 💡
بصفتنا شركاءك في الرحلة الصحية، نقدم لك خلاصة الخبرات السريرية للتعامل الذكي مع(ما هو فيروس كورونا):
- استثمر في مقياس التأكسج (Oximeter): وجود هذا الجهاز الصغير في منزلك أهم من تكديس الأدوية. معرفة مستوى الأكسجين مبكراً ينقذ الحياة قبل ظهور ضيق التنفس الواضح.
- لا تستلقِ على ظهرك طوال الوقت: قم بتغيير وضعيتك، وحاول النوم على بطنك وجانبيك لفتح الأجزاء الخلفية من الرئة ومنع تجمع السوائل (Collapsed Lung prevention).
- جهز “حقيبة الطوارئ المنزلية”: تحتوي على خافض حرارة، ميزان حرارة، سوائل تعويض الأملاح (ORS)، وأرقام الطوارئ الطبية.
- الهدوء النفسي نصف العلاج: التوتر يرفع الكورتيزول الذي يثبط المناعة. مارس تمارين التنفس العميق لتهدئة جهازك العصبي وتحسين كفاءة الرئتين.
أسئلة شائعة
كم مدة العزل الصحي المطلوبة حالياً؟
تختلف التوصيات، لكن الإرشادات العامة (مثل CDC) تقترح عزلاً لمدة 5 أيام على ألاقل من بدء الأعراض، يتبعها 5 أيام من ارتداء الكمامة بصرامة، بشرط اختفاء الحمى وتحسن الأعراض.
هل يمكن الإصابة بـ فيروس كورونا أكثر من مرة؟
نعم، المناعة المكتسبة (سواء من العدوى السابقة أو اللقاح) تتلاشى مع الوقت، كما أن المتحورات الجديدة قد تخترق هذه المناعة، لذا تتكرر الإصابات لكنها غالباً ما تكون أقل حدة.
هل اللقاح يمنع الإصابة تماماً؟
الهدف الرئيسي للقاح ليس منع العدوى بنسبة 100%، بل منع “المرض الشديد، دخول المستشفى، والوفاة”. هو يحول الفيروس من قاتل محتمل إلى نوبة مرضية يمكن السيطرة عليها.
ما الفرق بين الإنفلونزا وكوفيد-19؟
كلاهما فيروسات تنفسية، لكن فيروس كورونا يميل للانتشار بشكل أسرع، وفترة حضانته أطول، ويرتبط بمضاعفات أكثر خطورة مثل الجلطات ومتلازمة ما بعد المرض (Long COVID).
الخاتمة
إن التعامل مع (ما هو فيروس كورونا) يتطلب توازاً دقيقاً بين الحذر والوعي، بعيداً عن الهلع. الفهم العميق لطبيعة الفيروس، الالتزام بالإجراءات الوقائية، وسرعة التصرف عند ظهور أعراض التحذير، هي أدواتك الأقوى لعبور هذه الأزمة بسلام. في “بوابة HAEAT الطبية”، نؤكد أن العلم يتطور يومياً، ومتابعة المصادر الموثوقة هي سبيلك للحفاظ على صحتك وصحة أحبائك. لا تتردد في طلب المشورة الطبية فور شعورك بأي تغير صحي مقلق.
أقرأ أيضاً:



